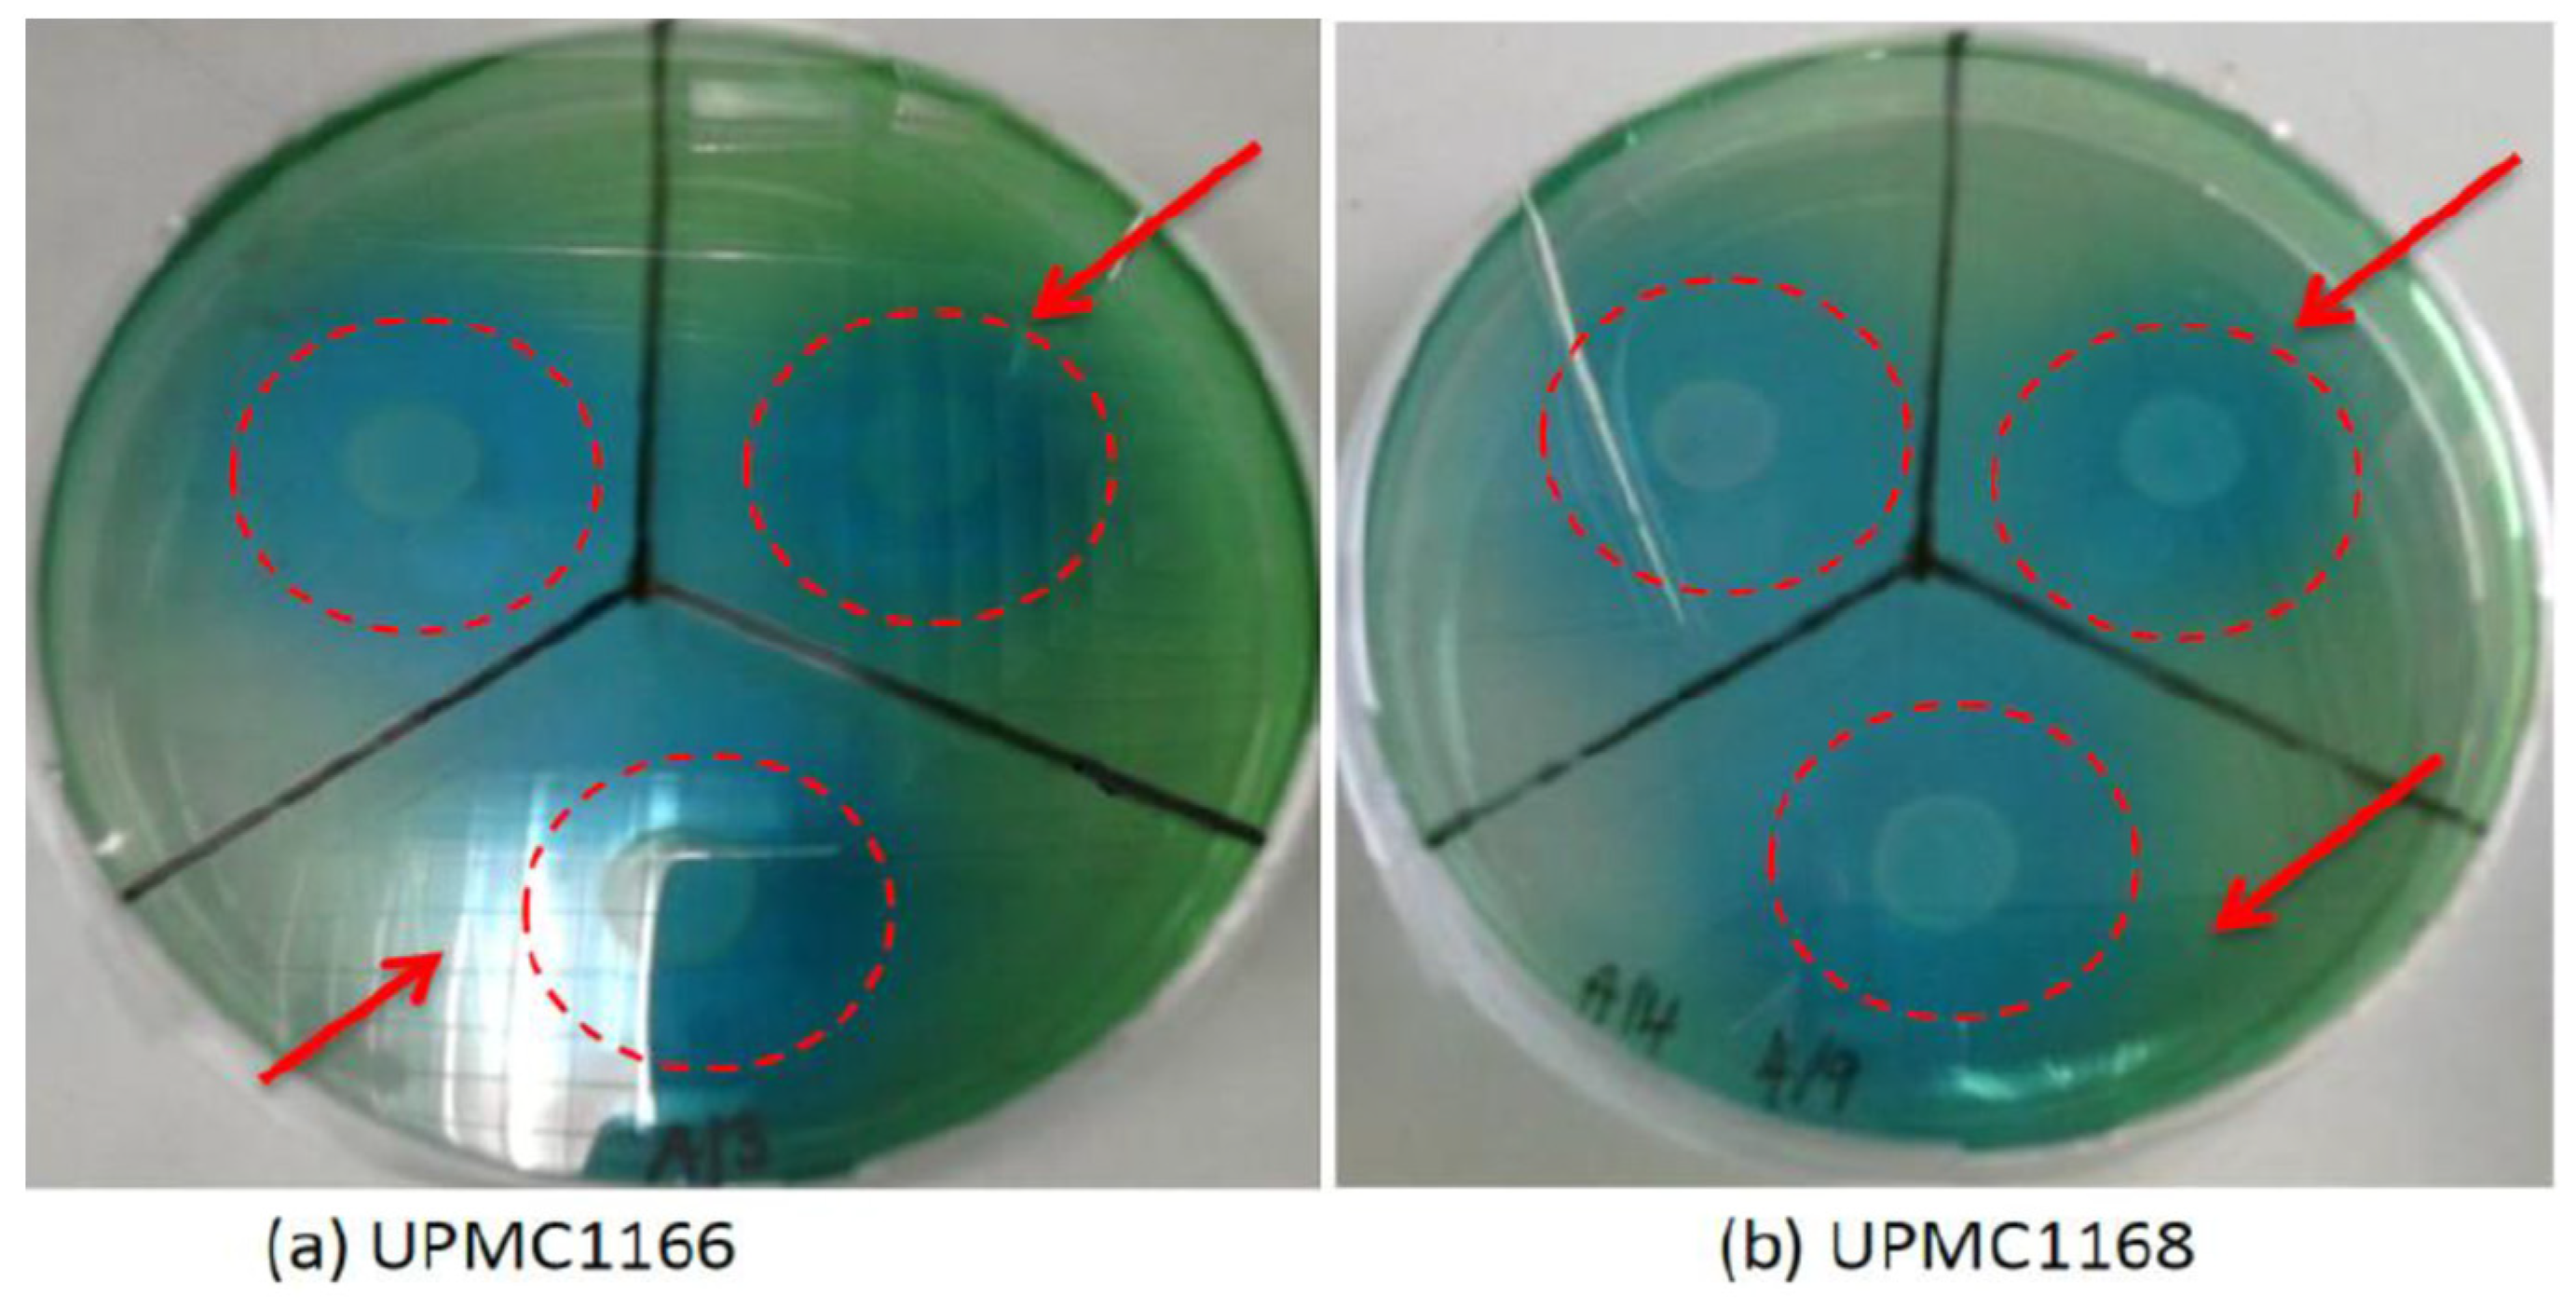
Applsci 13 07105 g001

Potential Novel Plant Growth Promoting Rhizobacteria for Bio-Organic Fertilizer Production in the Oil Palm (Elaeis guineensis Jacq.) in Malaysia
Abstract
1. Introduction
2. Materials and Methods
2.1. Sources of PGPR
2.2. Morphological and Biochemical Characterization of PGPR
2.2.1. Gram Stain
2.2.2. Catalase Test
2.2.3. pH and Salinity
- (a)
- pH
- (b)
- Salinity
2.2.4. Functionality Tests
- (a)
- Nitrogen fixation ability
- (b)
- Phosphate solubilization ability
- (c)
- Potassium solubilization ability
- (d)
- Phytohormone production
2.3. Genomic DNA Extraction
2.4. Statistical Analysis
3. Results and Discussion
3.1. Morphological and Biochemical Characterization of PGPR
3.2. Physiological Ability and Functionality Study
3.2.1. Nitrogen Fixation Ability
3.2.2. Phosphate Solubilization Ability
3.2.3. Potassium Solubilization Ability
3.2.4. Phytohormone Production
3.3. Identification of Potential Bacteria
4. Conclusions
Author Contributions
Funding
Institutional Review Board Statement
Informed Consent Statement
Data Availability Statement
Acknowledgments
Conflicts of Interest
References
- Kushairi, A.; Soh, K.L.; Azaman, I.; Elina, H.; Meilina-Ong, A.; Zanal, B.M.N.I.; Razimah, G.; Shamala, S.; Ghulam, K.A.P. Oil palm economic performance in Malaysia and R & D progress in 2017. J. Oil Palm Res. 2018, 30, 163–195. [Google Scholar]
- MPOC (Malaysian Palm Oil Council). Malaysian Palm Oil Industry. 2023. Available online: https://mpoc.org.my/malaysian-palm-oil-industry/ (accessed on 16 April 2023).
- Sarkar, M.S.K.; Begum, R.A.; Pereira, J.J. Impacts of climate change on oil palm production in Malaysia. Environ. Sci. Poll. Res. 2020, 27, 9760–9770. [Google Scholar] [CrossRef] [PubMed]
- Shahbandeh, M. Palm Oil: Global Production Volume 2012/13–2020/21. 2021. Available online: https://www.statista.com/statistics/613471/palm-oil-production-volume-worldwide/ (accessed on 4 December 2021).
- George, S.T.; Chung, G.F.; Zakaria, K. Updated results (1990–1995) on trunk injection of fungicides for the control of Ganoderma basal stem rot. In PORIM International Palm Oil Congress (Agriculture); Palm Oil Research Institute of Malaysia (PORIM): Bangi, Malaysia, 1996; pp. 508–515. [Google Scholar]
- Zubrod, J.P.; Bundschuh, M.; Arts, G.; Brühl, C.A.; Imfeld, G.; Knäbel, A.; Payraudeau, S.; Rasmussen, J.J.; Rohr, J.; Scharmüller, A.; et al. Fungicides: An overlooked pesticide class? Environ. Sci. Technol. 2019, 53, 3347–3365. [Google Scholar] [CrossRef] [PubMed]
- Castillo, C.; Huenchuleo, M.J.; Michaud, A.; Solano, J. Mycorrhizae in a potato crop added twin-N biofertilizer in an Andisol of the Araucanía Region. Idesia 2016, 34, 39–45. [Google Scholar] [CrossRef]
- Baset Mia, M.A.; Shamsuddin, Z.H. Rhizobium as a crop enhancer and biofertilizer for increased cereal production. Afr. J. Biotechnol. 2010, 9, 6001–6009. [Google Scholar]
- Tarmizi, A.M.; Mohd Tayed, D. Nutrient demand of Tenera oil palm planted on inland soils of Malaysia. J. Oil Palm Res. 2006, 18, 204–209. [Google Scholar]
- Stoltzfus, J.R.; So, R.; Malarvithi, P.P.; Ladha, J.K.; De Bruijn, F.J. Isolation of endophytic bacteria from rice and assessment of their potential for supplying rice with biologically fixed nitrogen. Plant Soil 1997, 194, 25–36. [Google Scholar] [CrossRef]
- Kumar, S.; Sindhu, S.S.; Kumar, R. Biofertilizers: An ecofriendly technology for nutrient recycling and environmental sustainability. Curr. Res. Microb. Sci. 2022, 3, 100094. [Google Scholar] [CrossRef]
- Kumari, R.; Singh, D.P. Nano-biofertilizer: An emerging eco-friendly approach for sustainable agriculture. Proceed. Nat. Acad. Sci. India Sec. B Biol. Sci. 2020, 90, 733–741. [Google Scholar] [CrossRef]
- Lima, F.A.; Viana, T.V.A.; de Sousa, G.G.; Correia, L.F.M.; de Azevedo, B.M. Yield of strawberry crops under different irrigation levels and biofertilizer doses. Rev. Cienc. Agron. 2018, 49, 381–388. [Google Scholar] [CrossRef]
- Pendey, A.; Palni, L.M.S.; Bag, N. Biological hardening of tissue culture raised tea plants through rhizosphere bacteria. Biotechnol. Lett. 2000, 22, 1087–1091. [Google Scholar] [CrossRef]
- Sturz, A.V.; Nowak, J. Endophytic communities of rhizobacteria and the strategies required to create yield enhancing associations with crops. Appl. Soil Ecol. 2000, 15, 183–190. [Google Scholar] [CrossRef]
- Azlin, C.O.; Amir, H.G.; Chan, L.K.; Zamzuri, I. Effect of plant growth promoting rhizobacteria on root formation and growth of tissue cultured oil palm (Elaeis guineensis Jacq.). Biotechnology 2007, 6, 549–554. [Google Scholar] [CrossRef]
- Mantelin, S.; Touraine, B. Plant growth promoting bacteria and nitrate availability: Impacts on root development and nitrate uptake. J. Exp. Bot. 2004, 55, 27–34. [Google Scholar] [CrossRef] [PubMed]
- Kefalogianni, I.; Anggelis, G. Modelling growth and biochemical activities of Azospirillum spp. Appl. Microbiol. Biotechnol. 2002, 58, 352–357. [Google Scholar] [PubMed]
- Bhattacharyya, P.N.; Jha, D.K. Plant growth-promoting rhizobacteria (PGPR): Emergence in agriculture. World J. Microbiol. Biotechnol. 2012, 28, 1327–1350. [Google Scholar] [CrossRef]
- Kumar, A.; Singh, V.; Singh, M.; Singh, P.P.; Singh, S.K.; Singh, P.K. Isolation of plant growth promoting rhizobacteria and their impact on growth and curcumin content in Curcuma longa L. Biocatal. Agric. Biotechnol. 2016, 8, 1–7. [Google Scholar] [CrossRef]
- Badri, D.V.; Weir, T.L.; van der Lelie, D.; Vivanco, J.M. Rhizosphere chemical dialogues: Plant-microbe interactions. Curr. Opin. Biotechnol. 2009, 20, 642–650. [Google Scholar] [CrossRef]
- Hayat, R.; Ali, S.; Amara, U.; Khalid, R.; Ahmed, I. Soil beneficial bacteria and their role in plant growth promotion: A review. Ann. Microbiol. 2010, 60, 579–598. [Google Scholar] [CrossRef]
- Lima, J.V.; Tinôco, R.S.; Olivares, F.L.; Chia, G.S.; de Melo Júnior, J.A.G.; da Silva, G.B. Rhizobacteria modify root architecture and improve nutrient uptake in oil palm seedlings despite reduced fertilizer. Rhizosphere 2021, 19, 100420. [Google Scholar] [CrossRef]
- Hastuti, P.B.; Wilisiani, F.; Gunawan, S.; Gaol, J.L.L.; Setyawan, H. Effect of rhizobacteria and palm mill byproducts on the growth of oil palm seedlings in a pre-nursery. KnE Life Sci. 2022, 7, 319–327. [Google Scholar] [CrossRef]
- Oubohssaine, M.; Dahmani, I.; Sbabou, L.; Bruneel, O.; Aurag, J. The rhizosphere of Sulla spinosissima growing in abandoned mining soils is a reservoir of heavy metals tolerant plant growth-promoting rhizobacteria. Biocatal. Agric. Biotechnol. 2022, 39, 102236. [Google Scholar] [CrossRef]
- Suryanti, S.; Umami, A.; Gunawan, S.; Santi, I.S.; Maulana, R.H. Influence of PGPR, bio-phosphate microorganism and phosphate on growth of oil palm seedlings under drought stress conditions. KnE Life Sci. 2022, 7, 427–434. [Google Scholar] [CrossRef]
- Zainuddin, N.; Keni, M.F.; Ibrahim, S.A.S.; Masri, M.M.M. Effect of integrated biofertilizers with chemical fertilizers on the oil palm growth and soil microbial diversity. Biocatal. Agric. Biotechnol. 2022, 39, 102237. [Google Scholar] [CrossRef]
- Kloepper, J.W. Plant growth-promoting rhizobacteria (other systems). In Azospirillum/Plant Association; Okon, Y., Ed.; CRC Press: Boca Raton, FL, USA, 1994; pp. 137–166. [Google Scholar]
- Lucy, M.; Reed, E.; Glick, B.R. Applications of free-living plant growth-promoting rhizobacteria. Antonie Leeu Wen Hoek 2004, 86, 1–25. [Google Scholar] [CrossRef] [PubMed]
- Raaijmakers, J.M.; Paulitz, T.C.; Steinberg, C.; Alabouvette, C.; Moënne-Loccoz, T. The rhizosphere: A playground and battlefield for soil-borne pathogens and beneficial microorganisms. Plant Soil 2009, 321, 341–361. [Google Scholar] [CrossRef]
- Ekin, Z. Performance of phosphate solubilizing bacteria for improving growth and yield of sunflower (Helianthus annuus L.) in the presence of phosphorus fertilizer. Afric. J. Biotechnol. 2010, 9, 3794–3800. [Google Scholar]
- De Freitas, J.; Banerjee, M.; Germida, J. Phosphate-solubilizing rhizobacteria enhance the growth and yield but not phosphorus uptake of canola (Brassica napus L.). Biol. Fert. Soils 1997, 24, 358–364. [Google Scholar] [CrossRef]
- Rahmoune, B.; Morsli, A.; Khelifi-Slaoui, M.; Khelifi, L.; Strueh, A.; Erban, A.; Kopka, J.; Prell, J.; van Dongen, J.T. Isolation and characterization of three new PGPR and their effects on the growth of Arabidopsis and Datura plants. J. Plant Interact. 2017, 12, 1–6. [Google Scholar] [CrossRef]
- Ajeng, A.A.; Abdullah, R.; Malek, M.A.; Chew, K.W.; Ho, Y.C.; Ling, T.C.; Lau, B.F.; Show, P.L. The effects of biofertilizers on growth, soil fertility, and nutrients uptake of oil palm (Elaeis guineensis) under greenhouse conditions. Processes 2020, 8, 1681. [Google Scholar] [CrossRef]
- Peng, S.H.T.; Yap, C.K.; Arshad, R.; Chai, E.W.; Priwiratama, H.; Hidayat, F.; Yanti, F.; Yulizar, F.; Pane, M.; Suprayetno, H. Efficacy of Hendersonia on the growth of seedlings of oil palm (Elaeis guineensis Jacq.) and Ganoderma disease control: A field-based study using GanoEF biofertilizer at Medan, Indonesia. MOJ Ecol. Environ. Sci. 2022, 7, 24–29. [Google Scholar] [CrossRef]
- Kloepper, J.W.; Leong, J.; Teinteze, M.; Schroth, M.N. Enhancing plant growth by siderophoress produced by plant growth promoting rhizobacteria. Nature 1980, 286, 885–886. [Google Scholar] [CrossRef]
- Sundram, S.; Meon, S.; Idris, A.S.; Othman, R. Application of arbuscular mycorrhizal fungi with Pseudomonas aeruginosa UPMP3 reduces the development of Ganoderma basal stem rot disease in oil palm seedlings. Mycorrhiza 2015, 25, 387–397. [Google Scholar] [CrossRef] [PubMed]
- Acevedo, E.; Galindo-Castaneda, T.; Prada, F.; Navia, M.; Romero, H.M. Phosphate-solubilizing microorganisms associated with the rhizosphere of oil palm (Elaeis guineensis Jacq.) in Colombia. Appl. Soil Ecol. 2014, 80, 26–33. [Google Scholar] [CrossRef]
- Situmorang, E.C.; Prameswara, A.; Sinthya, H.C.; Toruan-Mathius, N.; Liwang, T. Indigenous phosphate solubilizing bacteria from peat soil for an eco-friendly biofertilizer in oil palm plantation. KnE Energy 2015, 1, 65–72. [Google Scholar] [CrossRef]
- Vassileva, M.; Eichler-Löbermann, B.; Martos, V.; Vassilev, N. Sustainable crop production: P-solubilizing biofertilizers. Int. Multidiscip. Sci. GeoConf. Sur. Geol. Min. Ecol. Manag. 2018, 18, 653–660. [Google Scholar]
- Vessey, J.K. Plant growth promoting rhizobacteria as biofertilizers. Plant Soil 2003, 255, 571–586. [Google Scholar] [CrossRef]
- Azri, M.H.; Salmah, I.; Rosazlin, A. An endophytic Bacillus strain promotes growth of oil palm seedling by fine root biofilm formation. Rhizosphere 2018, 5, 1–7. [Google Scholar] [CrossRef]
- Tan, G.H.; Nazaruddin, S.A. Isolation, characterisation and identification of effective microorganisms from Malaysia biofertiliser products. Direct Res. J. Agric. Food Sci. 2015, 3, 157–161. [Google Scholar]
- Mansor, M.; Tan, G.H.; Nor Umaira, A.A.; Raha, A.R. Characterisation and effect of protectants on preservation of Bacillus methylotrophicus UPMC 1166 isolated from liquid biofertiliser. Pertanika J. Trop. Agric. Sci. 2018, 41, 1003–1020. [Google Scholar]
- Reiner, K. Catalase Test Protocol. 2010. Available online: https://www.asmscience.org/content/education/protocol/protocol.3226 (accessed on 30 April 2020).
- Logan, N.A.; Vos, P.D. Bacillus. In Bergey’s Manual of Systematics of Archaea and Bacteria; Wiley: Hoboken, NJ, USA, 2015; pp. 1–163. [Google Scholar]
- Brahmbhatt, D.; Modi, H.A. Comparative studies on methods of tannase assay. Int. J. Res. Appl. Sci. Eng. Technol. 2015, 3, 715–720. [Google Scholar]
- Dobereiner, J.; Day, J.M. Associative symbiosis in tropical grasses; Characterization of microorganism and dinitrogen fixing sites. In First Symposium on Nitrogen Fixation; Newton, W.E., Nyman, C.J., Eds.; Washington State University Press: Pullman, DC, USA, 1976; Volume 2, pp. 518–538. [Google Scholar]
- Joe, M.M.; Deivaraj, S.; Benson, A.; Henry, A.J.; Narendrakumar, G. Soil extract calcium phosphate media for screening of phosphate-solubilizing bacteria. Agric. Nat. Res. 2018, 52, 305–308. [Google Scholar] [CrossRef]
- Hu, X.; Chen, J.; Gu, J. Two phosphate- and potassium-solubilizing bacteria isolated from Tianmu Mountain, Zhejiang, China. World J. Microbiol. Biotechnol. 2006, 22, 983–990. [Google Scholar] [CrossRef]
- Gordon, S.A.; Weber, R.P. Colorimetric estimation indoleacetic acid. Plant Physiol. 1951, 26, 192–195. [Google Scholar] [CrossRef]
- Sambrook, J.; Maccallum, P.; Russel, D. Molecular Cloning: A Laboratory Manual, 3rd ed.; Cold Spring Harbor Press: Long Island, NY, USA, 2011; 2344p. [Google Scholar]
- Kumari, P.; Meena, M.; Upadhyay, R.S. Characterization of plant growth promoting rhizobacteria (PGPR) isolated from the rhizosphere of Vigna radiata (mung bean). Biocatal. Agric. Biotechnol. 2018, 16, 155–162. [Google Scholar] [CrossRef]
- Rashid, S.; Charles, T.C.; Glick, B.R. Isolation and characterization of new plant growth promoting bacterial endophytes. Appl. Soil Ecol. 2012, 61, 217–224. [Google Scholar] [CrossRef]
- Zhao, K.; Penttinen, P.; Zhang, X.; Ao, X.; Liu, M.; Yu, X.; Chen, Q. Maize rhizosphere in Sichuan, China, hosts plant growth promoting Burkholderia cepacia with phosphate solubilizing and antifungal abilities. Microbiol. Res. 2014, 169, 76–82. [Google Scholar] [CrossRef]
- Gayathri, S.; Saravanan, D.; Radhakrishnan, M.; Balagurunathan, R.; Kathiresan, K. Bioprospecting potential of fast growing endophytic bacteria from leaves of mangrove and salt-marsh plant species. Ind. J. Biotechnol. 2010, 9, 397–402. [Google Scholar]
- Ambardar, S.; Vakhlu, J. Plant growth promoting bacteria from Crocus sativus rhizosphere. World J. Microbiol. Biotechnol. 2013, 29, 2271–2279. [Google Scholar] [CrossRef]
- Toyota, K. Microbial interactions and activities affecting sago palm growth. In Sago Palm; Ehara, H., Toyoda, Y., Johnson, D., Eds.; Springer: Singapore, 2018. [Google Scholar]
- Ferreira, A.C.; Cozzolino, K.; Carvalho, A.R.V.; Dobereiner, J. Isolation and characterization of diazotrophic bacteria in oil palm trees. In International Symposium on Sustainable Agriculture for the Tropics—The Role of Biological Nitrogen Fixation; Boddey, R.M., Resende, A.S., Eds.; Embrapa: Rio de Janeiro, Brazil, 1995; pp. 210–211. [Google Scholar]
- Shamsuddin, M.M.; Rohani, A.W.; Roslina, C.N.; Noraga, H.O.; Chalk, P.M. Nitrogen fixation by Azospirillum in association with oil palm. In Proceedings of the International Symposium on Sustainable Agriculture for the Tropics—The Role of Biological Nitrogen Fixation, Rio de Janeiro, Brazil, 26 November–1 December 1995; Embrapa-CNPAB: Rio de Janeiro, Brazil, 1995. [Google Scholar]
- Dobereiner, J.; Baldani, V.L.D.; Reis, V.M. The role of biological nitrogen fixation to bio-energy programs in the tropics. In Transition to Global Sustainability: The Contribution of Brazilian Science, 1st ed.; Rocha-Miranda, C.E., Ed.; Academia Brasileira de Ciências: Rio de Janeiro, Brazil, 2000; pp. 195–208. [Google Scholar]
- Amir, H.G.; Shamsuddin, Z.H.; Halimi, M.S.; Ramlan, M.F.; Marziah, M. Effects of Azospirillum inoculation on N2 fixation and growth of oil palm plantlets at nursery stage. J. Oil Palm Res. 2001, 13, 42–49. [Google Scholar]
- Amir, H.G.; Shamsuddin, Z.H.; Halimi, M.S.; Marzian, M.; Ramlan, M.F. Enhancement in nutrient accumulation and growth of oil palm seedlings caused by PGPR under field nursery conditions. Commun. Soil Sci. Plant Anal. 2005, 36, 2059–2066. [Google Scholar] [CrossRef]
- Carvalho, A.L.V.; Alves, B.J.R.; Baldani, V.L.D.; Reis, V.M. Application of 15N natural abundance technique for evaluating biological nitrogen fixation in oil palm ecotypes at nursery stage in pot experiments and at mature plantation sites. Plant Soil 2008, 302, 71–78. [Google Scholar] [CrossRef][Green Version]
- Carvalho, A.V.; Alves, B.J.R.; Reis, V.M. Resposta do dendezeiro à adição de nitrogênio e sua influência na população de bactérias diazotróficas. Pesqui Agropecu Bras. 2006, 41, 293–300. [Google Scholar] [CrossRef][Green Version]
- Narula, N.; Gupta, K.G. Detection of ammonia excretors on agar plates. Zent. Microbiol. 1987, 142, 183–185. [Google Scholar] [CrossRef]
- Malleswari, D.; Bagyanarayana, G. In vitro screening of rhizobacteria isolated from the rhizosphere of m edicinal and aromatic plants for multiple plant growth promoting activities. J. Microbiol. Biotechnol. 2013, 3, 84–91. [Google Scholar]
- Bumunang, E.W.; Babalola, O.O. Characterization of rhizobacteria from field grown genetically modified (GM) and non-GM maizes. Braz. Arch. Biol. Technol. 2014, 57, 1–8. [Google Scholar] [CrossRef]
- Rodriguez, H.; Fraga, R. Phosphate solubilizing bacteria and their role in plant growth promotion. Biotechnol. Adv. 1999, 17, 319–339. [Google Scholar] [CrossRef]
- Modi, K.; Patel, P. Isolation and characterization of plant growth promoting rhizobacteria associated with Saccharum officinarum L. Curr. Syn. Syst. Biol. 2017, 5, 132. [Google Scholar] [CrossRef]
- Bhardwaj, G.; Shah, R.; Joshi, B.; Patel, P. Klebsiella pneumoniae VRE36 as a PGPR isolated from Saccharum officinarum cultivar Co99004. J. Appl. Biol. Biotechnol. 2017, 5, 47–52. [Google Scholar] [CrossRef]
- Fankem, H.; Nwaga, D.; Deubel, A.; Dieng, L.; Merbach, W.; Etoa, F.X. Occurrence and functioning of phosphate solubilizing microorganisms from oil palm tree (Elaeis guineensis) rhizosphere in Cameroon. Afr. J. Biotechnol. 2006, 5, 2450–2460. [Google Scholar]
- Ida Nur Istina, I.N.; Widiastuti, H.; Joy, B.; Antralina, M. Phosphate-solubilizing microbe from saprists peat soil and their potency to enhance oil palm growth and P uptake. Procedia Food Sci. 2015, 3, 426–435. [Google Scholar] [CrossRef]
- Bakhshandeh, E.; Pirdashti, H.; Lendeh, K. Phosphate and potassium-solubilizing bacteria effect on the growth of rice. Ecol. Eng. 2017, 103, 164–169. [Google Scholar] [CrossRef]
- Angraini, E.; Nisa Rachmania Mubarik, N.R.; Widyastuti, R. Study of potassium solubilizing bacteria from limestone mining area in Palimanan, Cirebon Quarry. Malays. J. Microbiol. 2016, 12, 62–68. [Google Scholar] [CrossRef]
- Dar, G.H.H.; Sofi, S.; Padder, S.A.; Kabli, A. Molecular characterization of rhizobacteria isolated from walnut (Juglans regia) rhizosphere in Western Himalayas and assessment of their plant growth promoting activities. Biodiversitas 2018, 19, 712–719. [Google Scholar] [CrossRef]
- Beneduzi, A.D.; Peres, L.K.; Vargas, M.H.; Bodanese-Zanettini, P. Evaluation of genetic diversity and plant growth promoting activities of nitrogen-fixing Bacilli isolated from rice fields in South Brazil. Appl. Soil Ecol. 2008, 39, 311–320. [Google Scholar] [CrossRef]
- Kaur, N.; Sharma, P. Screening and characterization of native Pseudomonas sp. as plant growth promoting rhizobacteria in chickpea (Cicer arietinum L.) rhizosphere. Afr. J. Microbiol. Res. 2013, 7, 1465–1474. [Google Scholar]
- Khin, M.L.; Moe, M.M.; Wai, Z.M.A. Isolation of plant hormone (indole-3-acetic acid-IAA) producing rhizobacteria and study on their effects on maize seedling. Eng. J. 2012, 16, 1–8. [Google Scholar]
- Husen, E. Screening of soil bacteria for plant growth promotion activities in vitro. Indones. J. Agric. Sci. 2003, 4, 27–31. [Google Scholar] [CrossRef]
- Shobha, G.; Kumudhini, B. Antagonistic effect of the newly isolated PGPR Bacillus spp. on Fusarium oxysporum. Int. J. Appl. Sci. Eng. Res. 2012, 1, 326–331. [Google Scholar]
- Ashrafuzzaman, M.; Hossen, F.A.; Ismail, M.R.; Hoque, M.A.; Islam, M.Z.; Shahidullah, S.M.; Meon, S. Efficiency of plant growth promoting rhizobacteria for the enhancement of rice growth. Afr. J. Biotechnol. 2009, 8, 1247–1252. [Google Scholar]
- Taghavi, S.; Garafola, C.; Monchy, S.; Newman, L.; Hoffman, A.; Weyens, N. Genome survey and characterization of endophytic bacteria exhibiting a beneficial effect on growth and development of poplar. Appl. Environ. Microbiol. 2009, 75, 748–757. [Google Scholar] [CrossRef] [PubMed]
- Laslo, E.; Gyorgy, E.; Mara, G.; Tamas, E.; Abraham, B.; Lanyi, S. Screening of plant growth promoting rhizobacteria as potential microbial inoculants. Crop Prot. 2012, 40, 43–48. [Google Scholar] [CrossRef]
- Glick, B.R. Plant growth-promoting bacteria: Mechanisms and applications. Scientifica 2012, 2012, 963401. [Google Scholar] [CrossRef]
- Maheshwari, D.K.; Dubey, R.C.; Aeron, A.; Kumar, B.; Kumar, S.; Tewari, S.; Arora, N.K. Integrated approach for disease management and growth enhancement of Sesamum indicum L. utilizing Azotobacter chrocccum TRA2 and chemical fertilizer. World J. Microbiol. Biotechnol. 2012, 28, 3015–3024. [Google Scholar] [CrossRef] [PubMed]
- Grobelak, A.; Kacprzak, M.; Grosser, A.; Napora, A. Chemophytostabilisation of soil contaminated with cadmium, lead and zinc. Ann. Set Environ. Prot. 2013, 15, 1982–2002. [Google Scholar]
- Grobelak, A.; Napora, A.; Kacprzak, M. Using plant growth-promoting rhizobacteria (PGPR) to improve plant growth. Ecol. Eng. 2015, 84, 22–28. [Google Scholar] [CrossRef]
- Piotrowska-Seget, Z.; Cycon, M.; Kozdroj, J. Metal-tolerant bacteria occurring in heavily polluted soil and mine spoil. Appl. Soil Ecol. 2005, 28, 237–246. [Google Scholar] [CrossRef]
- Kacprzak, M.; Bruchal, M. Exploitation of the limestone and reclamation of the post-mining areas on the example of the Górażdże limestone mine. Eng. Environ. Prot. 2011, 14, 49–58. (In Polish) [Google Scholar]

| Component | Volume per Reaction |
|---|---|
| 5 U/mL Taq Polymerase (Lucigen, USA) | 0.50 µL |
| 100 pmol/μL universal primers (Forward: 5′ GAG TTT GAT CCT GCT CAG 3′; BioSune Biotechnology Co., Ltd., China) | 0.25 µL |
| Deionized water | 140 µL |
| 2.5 mM dNTP mix, PCR Grade (Lucigen, USA) | 2.00 µL |
| 100 pmol/μL universal primers (Reverse: 5′ GTT ACC TTG TTA CGA CTT 3′, BioSune Biotechnology Co., Ltd., China) | 0.25 µL |
| 10 × Reaction buffer containing 15 mM MgCl2 (Lucigen, USA) | 2.50 µL |
| Genomic DNA as the template (50–200 ng) | 5.00 µL |
| Isolates | Shape | Pigmentation | Margin | Form | Elevation | Appearance |
|---|---|---|---|---|---|---|
| UPMC1166 | Rod-shaped | creamy white | undulate | Irregular | Convex | bumpy, shiny |
| UPMC1254 | Rod-shaped | creamy white | undulate | Irregular | Convex | bumpy, shiny |
| UPMC1168 | Rod-shaped | creamy white | undulate | filamentous | Umbonate | bumpy and shiny in the middle, dull in the side |
| UPMC1389 | coccus shaped | creamy white | Entire | Circular | Convex | bumpy, shiny |
| UPMC703 | Rod-shaped | creamy white | Entire | Circular | Convex | bumpy, shiny |
| UPMC1376 | coccus shaped | creamy white | Entire | Circular | Convex | bumpy, shiny |
| UPMC1393 | Rod-shaped | creamy white | undulate | Irregular | Convex | bumpy, shiny |
| UPMC704 | coccus shaped | creamy white | Entire | Circular | Convex | bumpy, shiny |
| Characteristics | Growth in NaCl (%) | Catalase Test | Indole Acetic Acid (IAA) Production | Growth at pH | ||||||||
|---|---|---|---|---|---|---|---|---|---|---|---|---|
| 2 | 5 | 10 | 15 | 2 | 4 | 6 | 7 | 8 | 9 | |||
| UPMC 1166 | + | + | + | + | + | + | + | + | + | + | + | + |
| UPMC 1168 | + | + | + | + | + | + | + | + | + | + | + | + |
| UPMC 1254 | + | + | + | + | + | + | + | + | + | + | + | + |
| UPMC 1389 | + | + | + | + | + | + | + | + | + | + | + | + |
| UPMC 1376 | + | + | + | + | - | - | - | + | + | + | + | + |
| UPMC 1393 | + | + | + | + | - | - | - | + | + | + | + | + |
| UPMC 703 | + | + | + | + | - | - | - | + | + | + | + | + |
| UPMC 704 | + | + | + | + | + | - | + | + | + | + | + | + |
| Characteristics | Nitrogen Fixation Ability (Diameter in cm) | Phosphate Solubilizing Ability (Diameter in cm) | Potassium Solubilizing Ability (Diameter in cm) |
|---|---|---|---|
| UPMC 1166 | +(4.50 ± 1.91 a) | −(0.00) | −(0.00) |
| UPMC 1168 | +(4.25 ± 1.71 a) | −(0.00) | −(0.00) |
| UPMC 1254 | +(2.50 ± 0.58 a) | −(0.00) | −(0.00) |
| UPMC 1389 | +(3.25 ± 3.20 a) | −(0.00) | +(4.75 ± 1.50 a) |
| UPMC 1376 | −(0.00) | +(3.00 ± 1.16 a) | −(0.00) |
| UPMC 1393 | −(0.00) | +(3.25 ± 0.96 a) | −(0.00) |
| UPMC 703 | −(0.00) | −(0.00) | +(3.75 ± 2.50 a) |
| UPMC 704 | −(0.00) | −(0.00) | +(4.25 ± 1.5 a) |
| Isolates | ID | Similarity (%) |
|---|---|---|
| UPMC 1166 | Bacillus methylotrophicus | 99.0% |
| UPMC 1168 | Bacillus siamensis | 99.0% |
| UPMC 1254 | Bacillus subtilis | 99.9% |
| UPMC 1389 | Bacillus albus | 99.0% |
| UPMC 1376 | Lactobacillus plantarum | 100% |
| UPMC 1393 | Bacillus marisflavi | 98.8% |
| UPMC 703 | Burkholderia anthina | 99.4% |
| UPMC 704 | Burkholderia metallica | 98.9% |
Disclaimer/Publisher’s Note: The statements, opinions and data contained in all publications are solely those of the individual author(s) and contributor(s) and not of MDPI and/or the editor(s). MDPI and/or the editor(s) disclaim responsibility for any injury to people or property resulting from any ideas, methods, instructions or products referred to in the content. |
© 2023 by the authors. Licensee MDPI, Basel, Switzerland. This article is an open access article distributed under the terms and conditions of the Creative Commons Attribution (CC BY) license (https://creativecommons.org/licenses/by/4.0/).
Share and Cite
Peng, S.H.T.; Chee, K.H.; Saud, H.M.; Yusop, M.R.; Tan, G.H. Potential Novel Plant Growth Promoting Rhizobacteria for Bio-Organic Fertilizer Production in the Oil Palm (Elaeis guineensis Jacq.) in Malaysia. Appl. Sci. 2023, 13, 7105. https://doi.org/10.3390/app13127105
Peng SHT, Chee KH, Saud HM, Yusop MR, Tan GH. Potential Novel Plant Growth Promoting Rhizobacteria for Bio-Organic Fertilizer Production in the Oil Palm (Elaeis guineensis Jacq.) in Malaysia. Applied Sciences. 2023; 13(12):7105. https://doi.org/10.3390/app13127105
Chicago/Turabian StylePeng, Shih Hao Tony, Kheng Hoy Chee, Halimi Mohd Saud, Mohd Rafii Yusop, and Geok Hun Tan. 2023. "Potential Novel Plant Growth Promoting Rhizobacteria for Bio-Organic Fertilizer Production in the Oil Palm (Elaeis guineensis Jacq.) in Malaysia" Applied Sciences 13, no. 12: 7105. https://doi.org/10.3390/app13127105
APA StylePeng, S. H. T., Chee, K. H., Saud, H. M., Yusop, M. R., & Tan, G. H. (2023). Potential Novel Plant Growth Promoting Rhizobacteria for Bio-Organic Fertilizer Production in the Oil Palm (Elaeis guineensis Jacq.) in Malaysia. Applied Sciences, 13(12), 7105. https://doi.org/10.3390/app13127105

